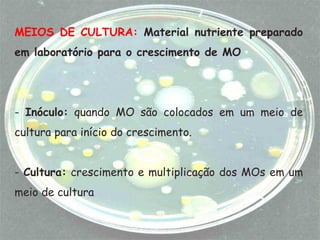
MEIOS DE CULTURA: Material nutriente preparado
em laboratório para o crescimento de MO
- Inóculo: quando MO são colocados em um meio de
cultura para início do crescimento.
- Cultura: crescimento e multiplicação dos MOs em um
meio de cultura
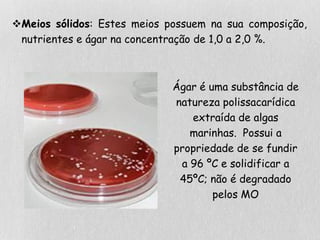
Meios sólidos: Estes meios possuem na sua composição,
nutrientes e ágar na concentração de 1,0 a 2,0 %.
Ágar é uma substância de
natureza polissacarídica
extraída de algas
marinhas. Possui a
propriedade de se fundir
a 96 ºC e solidificar a
45ºC; não é degradado
pelos MO
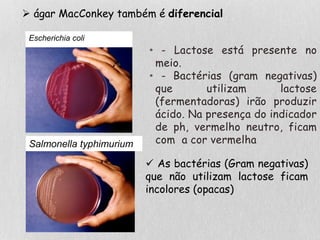
• - Lactose está presente no
meio.
• - Bactérias (gram negativas)
que utilizam lactose
(fermentadoras) irão produzir
ácido. Na presença do indicador
de ph, vermelho neutro, ficam
com a cor vermelha
 As bactérias (Gram negativas)
que não utilizam lactose ficam
incolores (opacas)
Salmonella typhimurium
Escherichia coli
 ágar MacConkey também é diferencial
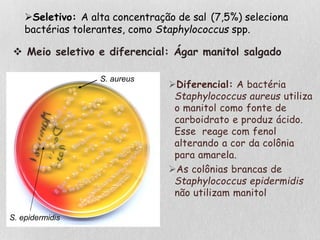
 Meio seletivo e diferencial: Ágar manitol salgado
Diferencial: A bactéria
Staphylococcus aureus utiliza
o manitol como fonte de
carboidrato e produz ácido.
Esse reage com fenol
alterando a cor da colônia
para amarela.
As colônias brancas de
Staphylococcus epidermidis
não utilizam manitol
Seletivo: A alta concentração de sal (7,5%) seleciona
bactérias tolerantes, como Staphylococcus spp.
S. aureus
S. epidermidis

O documento discute fatores que afetam o crescimento microbiano, incluindo temperatura, pH, pressão hidrostática e osmótica, e fontes de nutrientes. Fatores como temperatura, pH e pressão afetam a taxa e capacidade de crescimento, enquanto fontes adequadas de carbono, nitrogênio, fósforo e outros nutrientes são necessárias para o crescimento. O documento também descreve diferentes tipos de meios de cultura usados para cultivar microrganismos em laboratório.